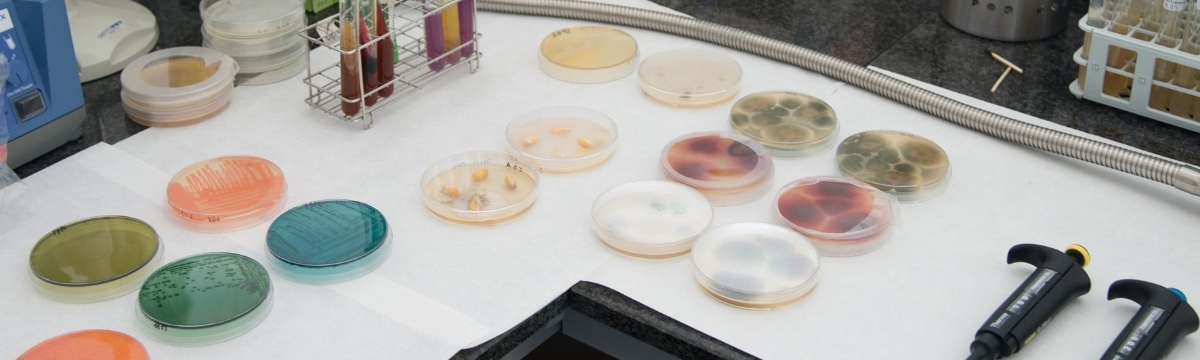

- Adreça
Campus ETSEA
Edifici 5A - SCT Qualitat microbiològica en el sector agroalimentari
Av. Alcalde Rovira Roure, 191
C.P.: 25198
Lleida
Qualitat microbiològica en el sector agroalimentari

El SCT Qualitat Microbiològica en el Sector Agroalimentari ofereix anàlisis microbiològiques d'aliments, pinsos i aigües, així com suport tècnic, assessorament científic i formació de manipuladors d'aliments.

l SCT cobreix un ampli espectre de microorganismes, especialment els que ocasionen problemes en els aliments, ja sigui perquè són l'origen de la seva alteració microbiològica o perquè es tracta de microorganismes patògens. Les determinacions es realitzen seguint les estrictes normes ISO o AFNOR.
D'altra banda, el SCT està especialitzat en l'aïllament i identificació de floridures en aliments i pinsos, en la determinació de micotoxines, i en l'avaluació de l'eficàcia de compostos adsorbents de micotoxines.
- Recompte de microorganismes aerobis mesòfils a 30 °C.
- Recompte de floridures i llevats
- Recompte de Enterobacteriaceae
- Recompte de coliformes
- Recompte de coliformes termotolerants
- Recompte de Escherichia coli
- Recompte de Clostridium perfringens
- Recompte de estafilococs coagulasa positius (Staphylococcus aureus)
- Recompte de Bacillus cereus
- Recompte d'anaerobis sulfito-reductors
- Recompte de bacteris anaerobis
- Recompte d'estreptococs fecals
- Recompte de bacteris làctics
- Recompte d'espores a 30 °C
- Recompte d'espores a 55 °C
- Investigació de Salmonella
- Investigació de Listeria monocytogenes
- Investigació de Alicyclobacillus sp.
- Anàlisi microbiològica completa d'aigües
- Control d'estabilitat i esterilitat de conserves (amb o sense identificació d'espècies)
- Identificació de microorganismes per tècniques culturals i/o microscòpiques
- Identificació de microorganismes mitjançant tires API
- Identificació de microorganismes mitjançant tècniques de Biologia Molecular
- Avaluació de l'activitat bactericida o fungicida de compostos.
- Altres determinacions a demanda del client
- Aïllament i identificació de floridures a nivell de gènere o d'espècie
- Anàlisi de micotoxines en aliments (mètode ELISA o HPLC): aflatoxines, zearalenona, fumonisines, ocratoxines, tricotecens (deoxinivalenol, toxina T-2, diacetoxiscirpenol), patulina, etc. Anàlisi de micotoxines conjugades.
- Determinació de l'eficàcia de compostos adsorbents de micotoxines
- Determinació de l'activitat d'aigua d'aliments
- Control microbiològic d'aire, superfícies i manipuladors
- Cursos de manipuladors d'aliments
- Realització de cursos pràctics de formació i/o reciclatge en tècniques d'anàlisis microbiològiques per a grups reduïts
- Assessorament científic per a la implantació del sistema APPCC
El SCT s'ofereix també en forma d'autoservei per a usuaris que acreditin la seva competència en tècniques microbiològiques.
El SCT disposa de l'equipament complet d'un laboratori de microbiologia, incloent cabines de fluxe laminar, autoclaus, estufes, incubadores, orbitals, masticadors, pH-metres, agitadors, microscopis, centrífugues, etc.
D'altra banda compta amb equipament per a la determinació de micotoxines per tècniques ELISA (lector de plaques) o HPLC (sistema cromatogràfic HPLC i UPCL amb detectors de fluorescència i díode array).
També compta amb un laboratori de Biologia molecular equipat amb el necessari per dur a terme la identificació d'espècies, incloent un PCR.
Director del Servei
Dr. Antonio J. Ramos Girona
Correu electrònic: ajramos@tecal.udl.es
Telèfon de contacte: +34 973702811
Personal Tècnic
Sr. Robert Garrofé Forcat
Correu electrònic: robert.garrofe@udl.cat
Telèfon de contacte: +34 973706477
Altre Personal
Dr. Vicente Sanchis Almenar
Correu electrònic: vsanchis@tecal.udl.es
Telèfon de contacte: +34 973702535
--------------------------------------------------------------------------------------
Dra. Sonia Marín Sillué
Correu electrònic: smarin@tecal.udl.cat
Telèfon de contacte: +34 973702542





